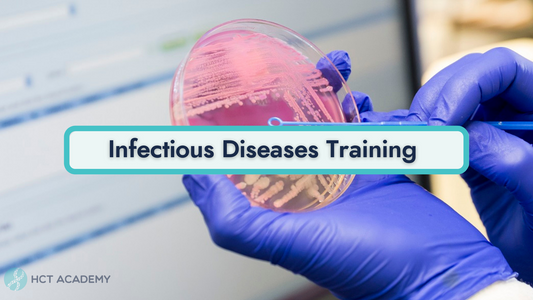

Collection: Products
-

Improve your sex life, blood circulation and digestion with the Hip Wipers, Frog Pose and Hip Flexor
Regular price ₱0.00 PHPRegular priceUnit price / per -
Infection Control Pro Bundle
Regular price ₱1,000.00 PHPRegular priceUnit price / per -
Infectious Diseases Training
Regular price ₱1,200.00 PHPRegular priceUnit price / per -
Infectious Diseases [Bundled Course]
Regular price ₱300.00 PHPRegular priceUnit price / per -
Insider's Guide: Learning statistics when you're short on time finishing a thesis or research paper
Regular price ₱300.00 PHPRegular priceUnit price / per -
Intensive Physical Assessment
Regular price ₱1,000.00 PHPRegular priceUnit price / per -
Intravenous Therapy (IVT) with Blood Transfusion (BT) Admnistration and Management [Bundle Course]
Regular price ₱500.00 PHPRegular priceUnit price / per -
Introduction to Microbiology
Regular price ₱1,000.00 PHPRegular priceUnit price / per -
JCI Accreditation Participation Requirements (APR)
Regular price ₱300.00 PHPRegular priceUnit price / per -
JCI: Assessment of Patient (AOP)
Regular price ₱300.00 PHPRegular priceUnit price / per -
Joint Commission International (JCI) Full Course (5 days)
Regular price ₱20,000.00 PHPRegular priceUnit price / per -
Learn How to do Deep Squat in 1 minute to keep joints flexible and strong
Regular price ₱300.00 PHPRegular priceUnit price / per

![Infectious Diseases [Bundled Course] Thinkific](http://www.hct.ph/cdn/shop/products/KjjA3cuITkiIsxfUF6tb_WhatsAppImage2022-08-11at9.59.31PM_4_1.webp?v=1753069963&width=533)


![Intravenous Therapy (IVT) with Blood Transfusion (BT) Admnistration and Management [Bundle Course] Thinkific](http://www.hct.ph/cdn/shop/files/IntravenousTherapy_IVT_withBloodTransfusion_BT_AdmnistrationandManagement_Bundle_-01.png?v=1753070761&width=533)




